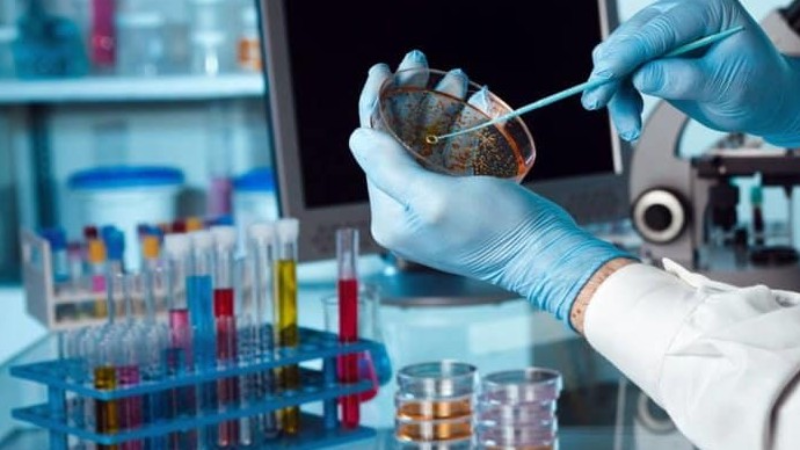
Screenshot-2025-07-08-182438 Rede global de materiais biológicos sediará seu primeiro polo no Brasil

A Universidade de São Paulo (USP) foi escolhida para abrigar o primeiro polo brasileiro da Reagent Collaboration Network (Reclone), uma rede internacional que atua em mais de 50 países com o objetivo de democratizar o acesso a materiais biológicos.
Iniciativa internacional chega ao Brasil com primeiro polo
O polo será responsável por produzir e distribuir, gratuitamente, reagentes e biomateriais a universidades, laboratórios e centros de pesquisa de todo o país.
A Reclone nasceu com a missão de tornar o conhecimento científico mais acessível, fornecendo a pesquisadores de áreas biomédicas ferramentas de baixo custo, fundamentais para o avanço da ciência e da inovação.
Parceria entre Brasil e Reino Unido
O projeto no Brasil é coordenado pela professora Andrea Balan, do Instituto de Ciências Biomédicas da USP (ICB-USP), em colaboração com o professor Marko Hyvönen, da Universidade de Cambridge, no Reino Unido. A instalação do polo na capital paulista integra uma pesquisa financiada pela FAPESP através do programa São Paulo Excellence Chair (SPEC).
Além de fortalecer a produção local de enzimas e reagentes, o programa também está voltado ao estudo da resistência antimicrobiana, com o objetivo de fomentar o desenvolvimento de novos agentes terapêuticos contra microrganismos resistentes a múltiplas drogas.
Produção local e acesso gratuito
Com a chegada de uma coleção de enzimas trazida por Hyvönen, o polo começa agora a distribuição de materiais para pesquisadores interessados. A proposta é que a USP sirva como centro de produção de enzimas essenciais para a biologia molecular, beneficiando tanto suas próprias unidades quanto outras instituições em todo o território nacional.
“Queremos que pesquisadores em diferentes partes do Brasil tenham acesso a esses materiais sem custo, o que representa uma enorme economia frente aos preços praticados no mercado”, explicou Balan.
Formação e autonomia científica
Além de fornecer materiais, o polo brasileiro da Reclone irá capacitar profissionais por meio de cursos e kits de treinamento. A meta é ensinar pesquisadores a produzir seus próprios reagentes, promovendo a autonomia científica em locais com pouco ou nenhum financiamento.
A equipe responsável pretende expandir essas ações para regiões menos favorecidas, incentivando o desenvolvimento de pesquisas tanto básicas quanto aplicadas. “Com isso, esperamos ampliar o impacto da ciência brasileira e tornar a produção de conhecimento mais inclusiva e sustentável”, destacou Hyvönen.

Expansão latino-americana
O novo polo também atuará em articulação com outros centros da Reclone na América Latina, localizados na Argentina, Chile e Peru. Todos esses polos recebem apoio da Iniciativa Chan Zuckerberg, organização voltada ao fomento da pesquisa biomédica global.
A expectativa é que o Brasil contribua de forma ativa na consolidação da estrutura regional da Reclone, participando de projetos colaborativos e compartilhando soluções que beneficiem a ciência latino-americana como um todo.
Fonte: Agência FAPESP











Você precisa fazer login para comentar.